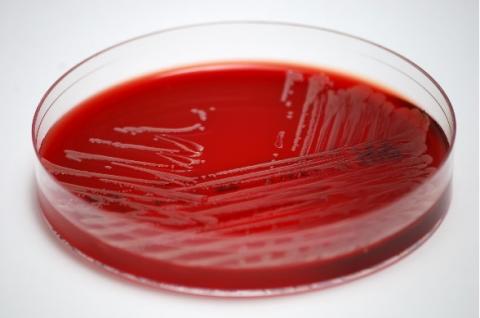
Culture de Staphylococcus aureus

STATINES : Elles semblent réduire le risque d’infections bactériennes sévères

L'utilisation de statines semble réduire le risque d'une infection bactérienne grave révèle cette étude des hôpitaux universitaires d'Aalborg et d'Aarhus (Danemark) et de l'hôpital universitaire de Séville (Espagne) publiée dans Mayo Clinic Proceedings. Ici, l'utilisation de statines s’avère associée à une diminution significative du risque d'infection sanguine par Staphylococcus aureus.
Les patients qui prennent des statines en prévention des la maladie cardiaque, présentent un risque réduit de 27% de contracter une infection du sang par Staphylococcus aureus (S. aureus), ici en dehors de l’hôpital. Ces données se révèlent tout particulièrement importantes chez les patients âgés atteints de maladies chroniques préexistantes telles que le diabète, la maladie rénale ou hépatique. Plus globalement, ces résultats sont précieux en regard de l’« épidémie » actuelle de maladies chroniques : cet effet préventif des statines pourrait en effet avoir d'importantes implications en Santé publique. Rappelons que S. aureus est une bactérie qui peut coloniser la peau, causer une infection sévère, qui peut être fatale si les bactéries se propagent dans la circulation sanguine.
Par ailleurs, les statines sont parmi les médicaments les plus utilisés pour la prévention des maladies cardiovasculaires.
Les chercheurs ont analysé à partir des registres, les données de près de 30.000 patients suivis sur une période de 12 ans. 2.638 cas de bactériémie à S. aureus acquis en communauté ont été recensés. 26.379 témoins ont été appariés aux cas sur l'âge, le sexe et le lieu de vie.
- Chez les cas, 14,0% étaient des utilisateurs actuels de statines ;
- Chez les témoins, seulement 12,2%.
Un effet préventif dose-dépendant : L'équipe a également regardé le risque d'infection en tenant compte de l’antériorité du traitement par statines, de la dose cumulée sur 90 jours et chez des sous-groupes spécifiques de patients recevant des statines pour différentes affections chroniques comme un antécédent d’infarctus du myocarde, la maladie artérielle périphérique, l’insuffisance cardiaque chronique, la maladie rénale chronique et le diabète. Cette analyse constate que :
- le risque diminue progressivement avec l'augmentation du dosage des statines,
- l'association est plus forte chez les patients souffrant de maladie rénale chronique et de diabète ;
- les utilisateurs actuels de statines bénéficient d’une réduction de 27% du risque d’infection,
- les utilisateurs à long terme (plusieurs prescriptions sur plus de 90 jours) d’une réduction de 30% du risque d’infection,
- les nouveaux utilisateurs (première prescription au cours des 90 derniers jours ) d’un réduction du risque d’infection plus modeste, soit 4%.
Les statines pourraient donc occuper une place importante dans la prévention de l'infection sanguine causée par S. aureus, écrivent les chercheurs, avec des implications importantes en Santé publique. Néanmoins les auteurs souhaitent valider cet effet dans d'autres contextes et mieux comprendre les mécanismes biologiques sous-jacents à ce bénéfice.
Mais la question est posée des effets antimicrobiens avec cet avantage cliniquement pertinent, cette résistance aux infections communautaires.
Autres actualités sur le même thème
PLAIES DIABÉTIQUES : Une enzyme essentielle à la reprise de la cicatrisation
Actualité publiée il y a 3 années 2 moisVIVRE avec une PLAIE: L'importance des facteurs psychologiques
Actualité publiée il y a 10 années 2 moisCICATRISATION: Les glandes sudoripares, l'arme secrète pour mieux cicatriser
Actualité publiée il y a 9 années 7 moisINFECTION URINAIRE : La métamorphose de la bactérie en dit long
Actualité publiée il y a 3 années 8 mois




